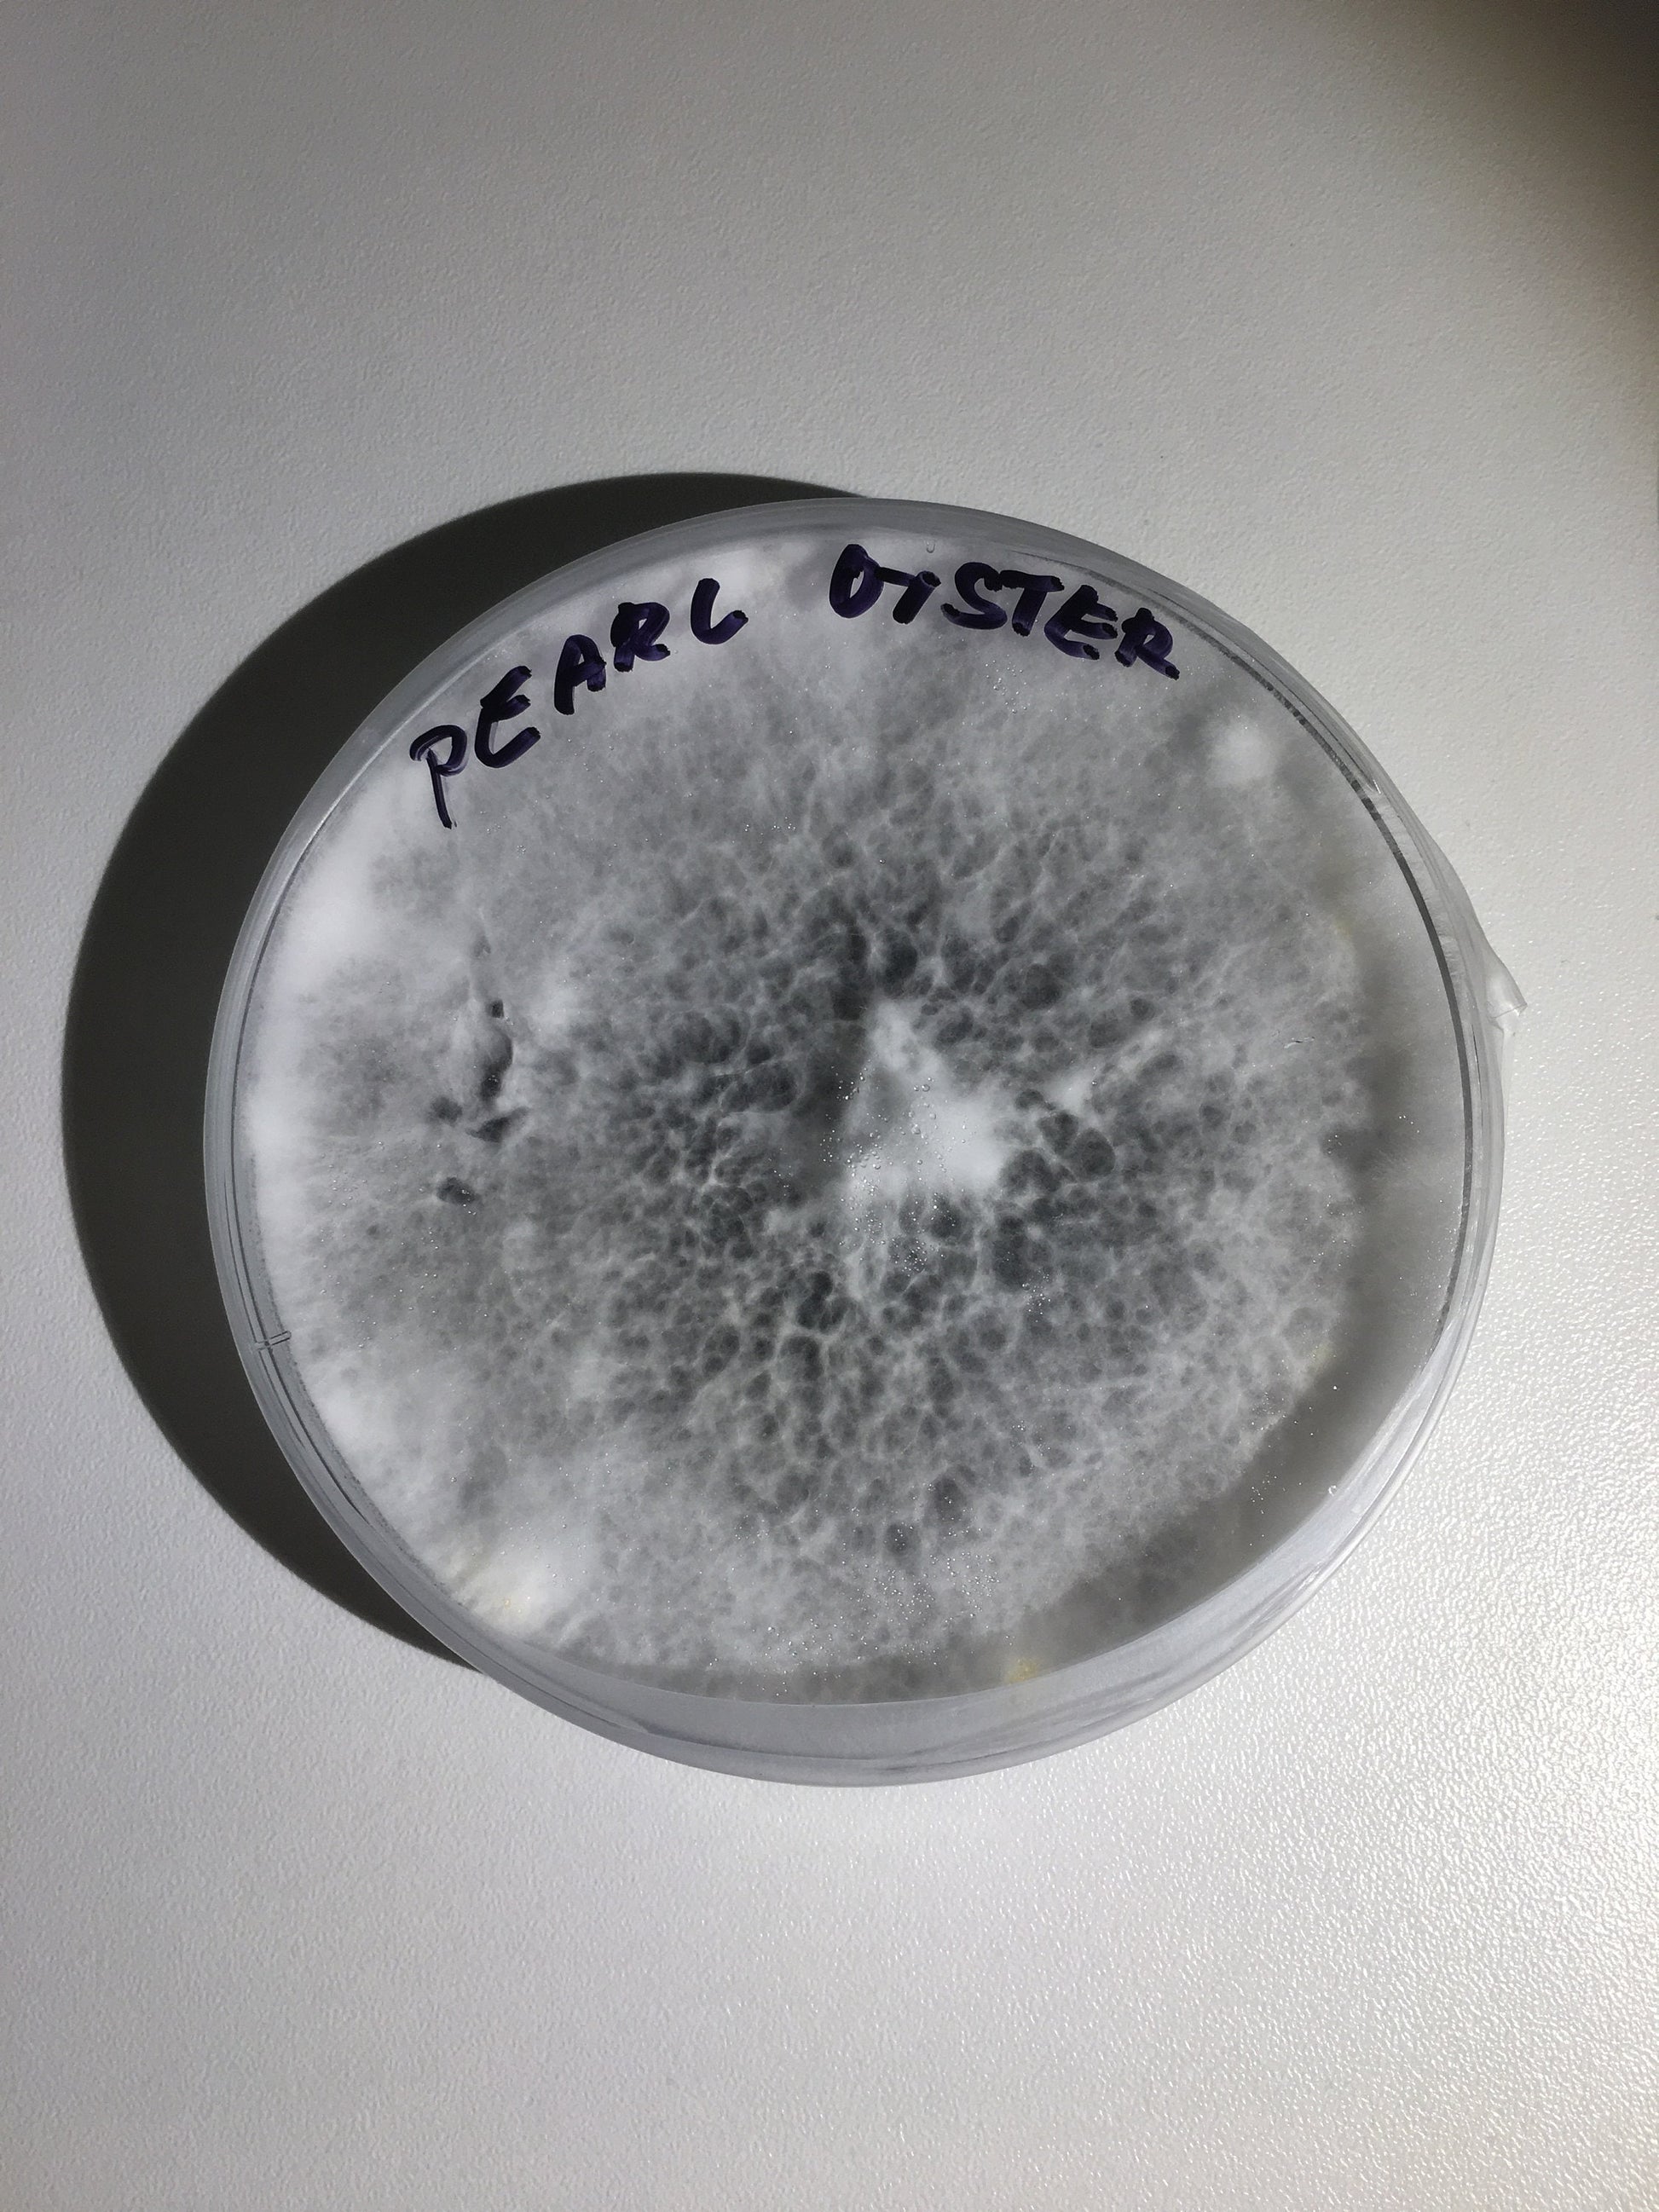
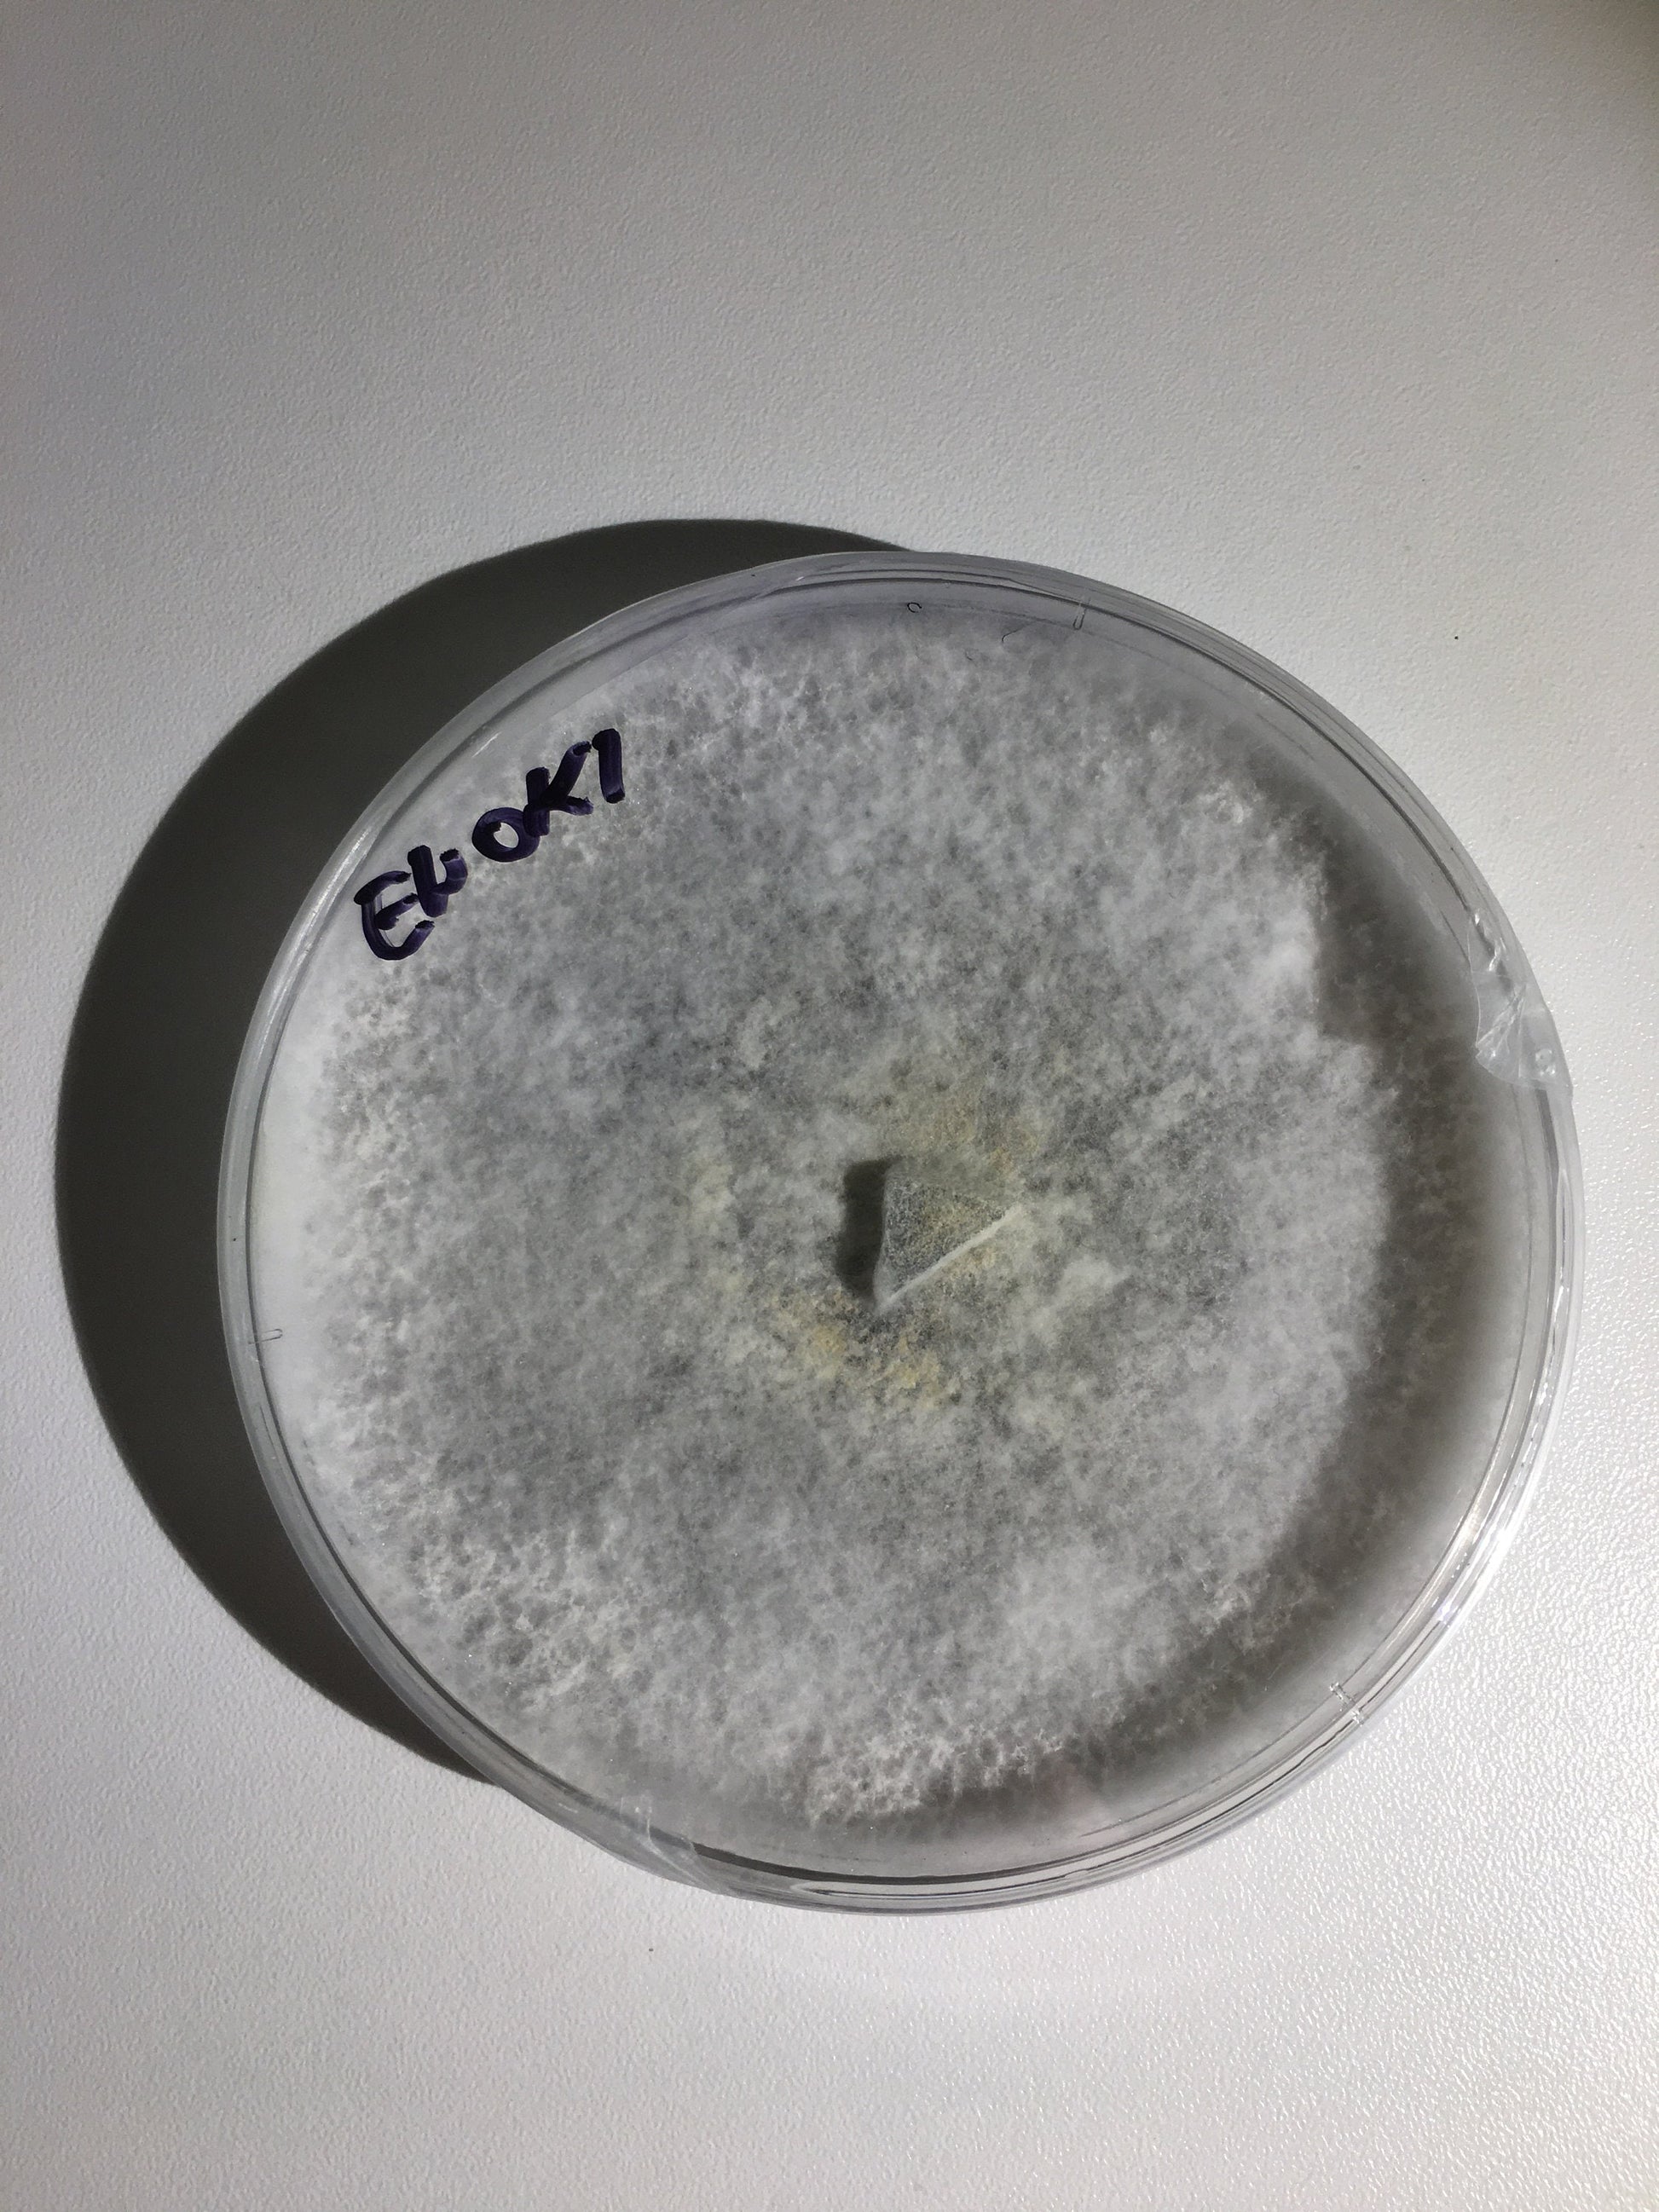
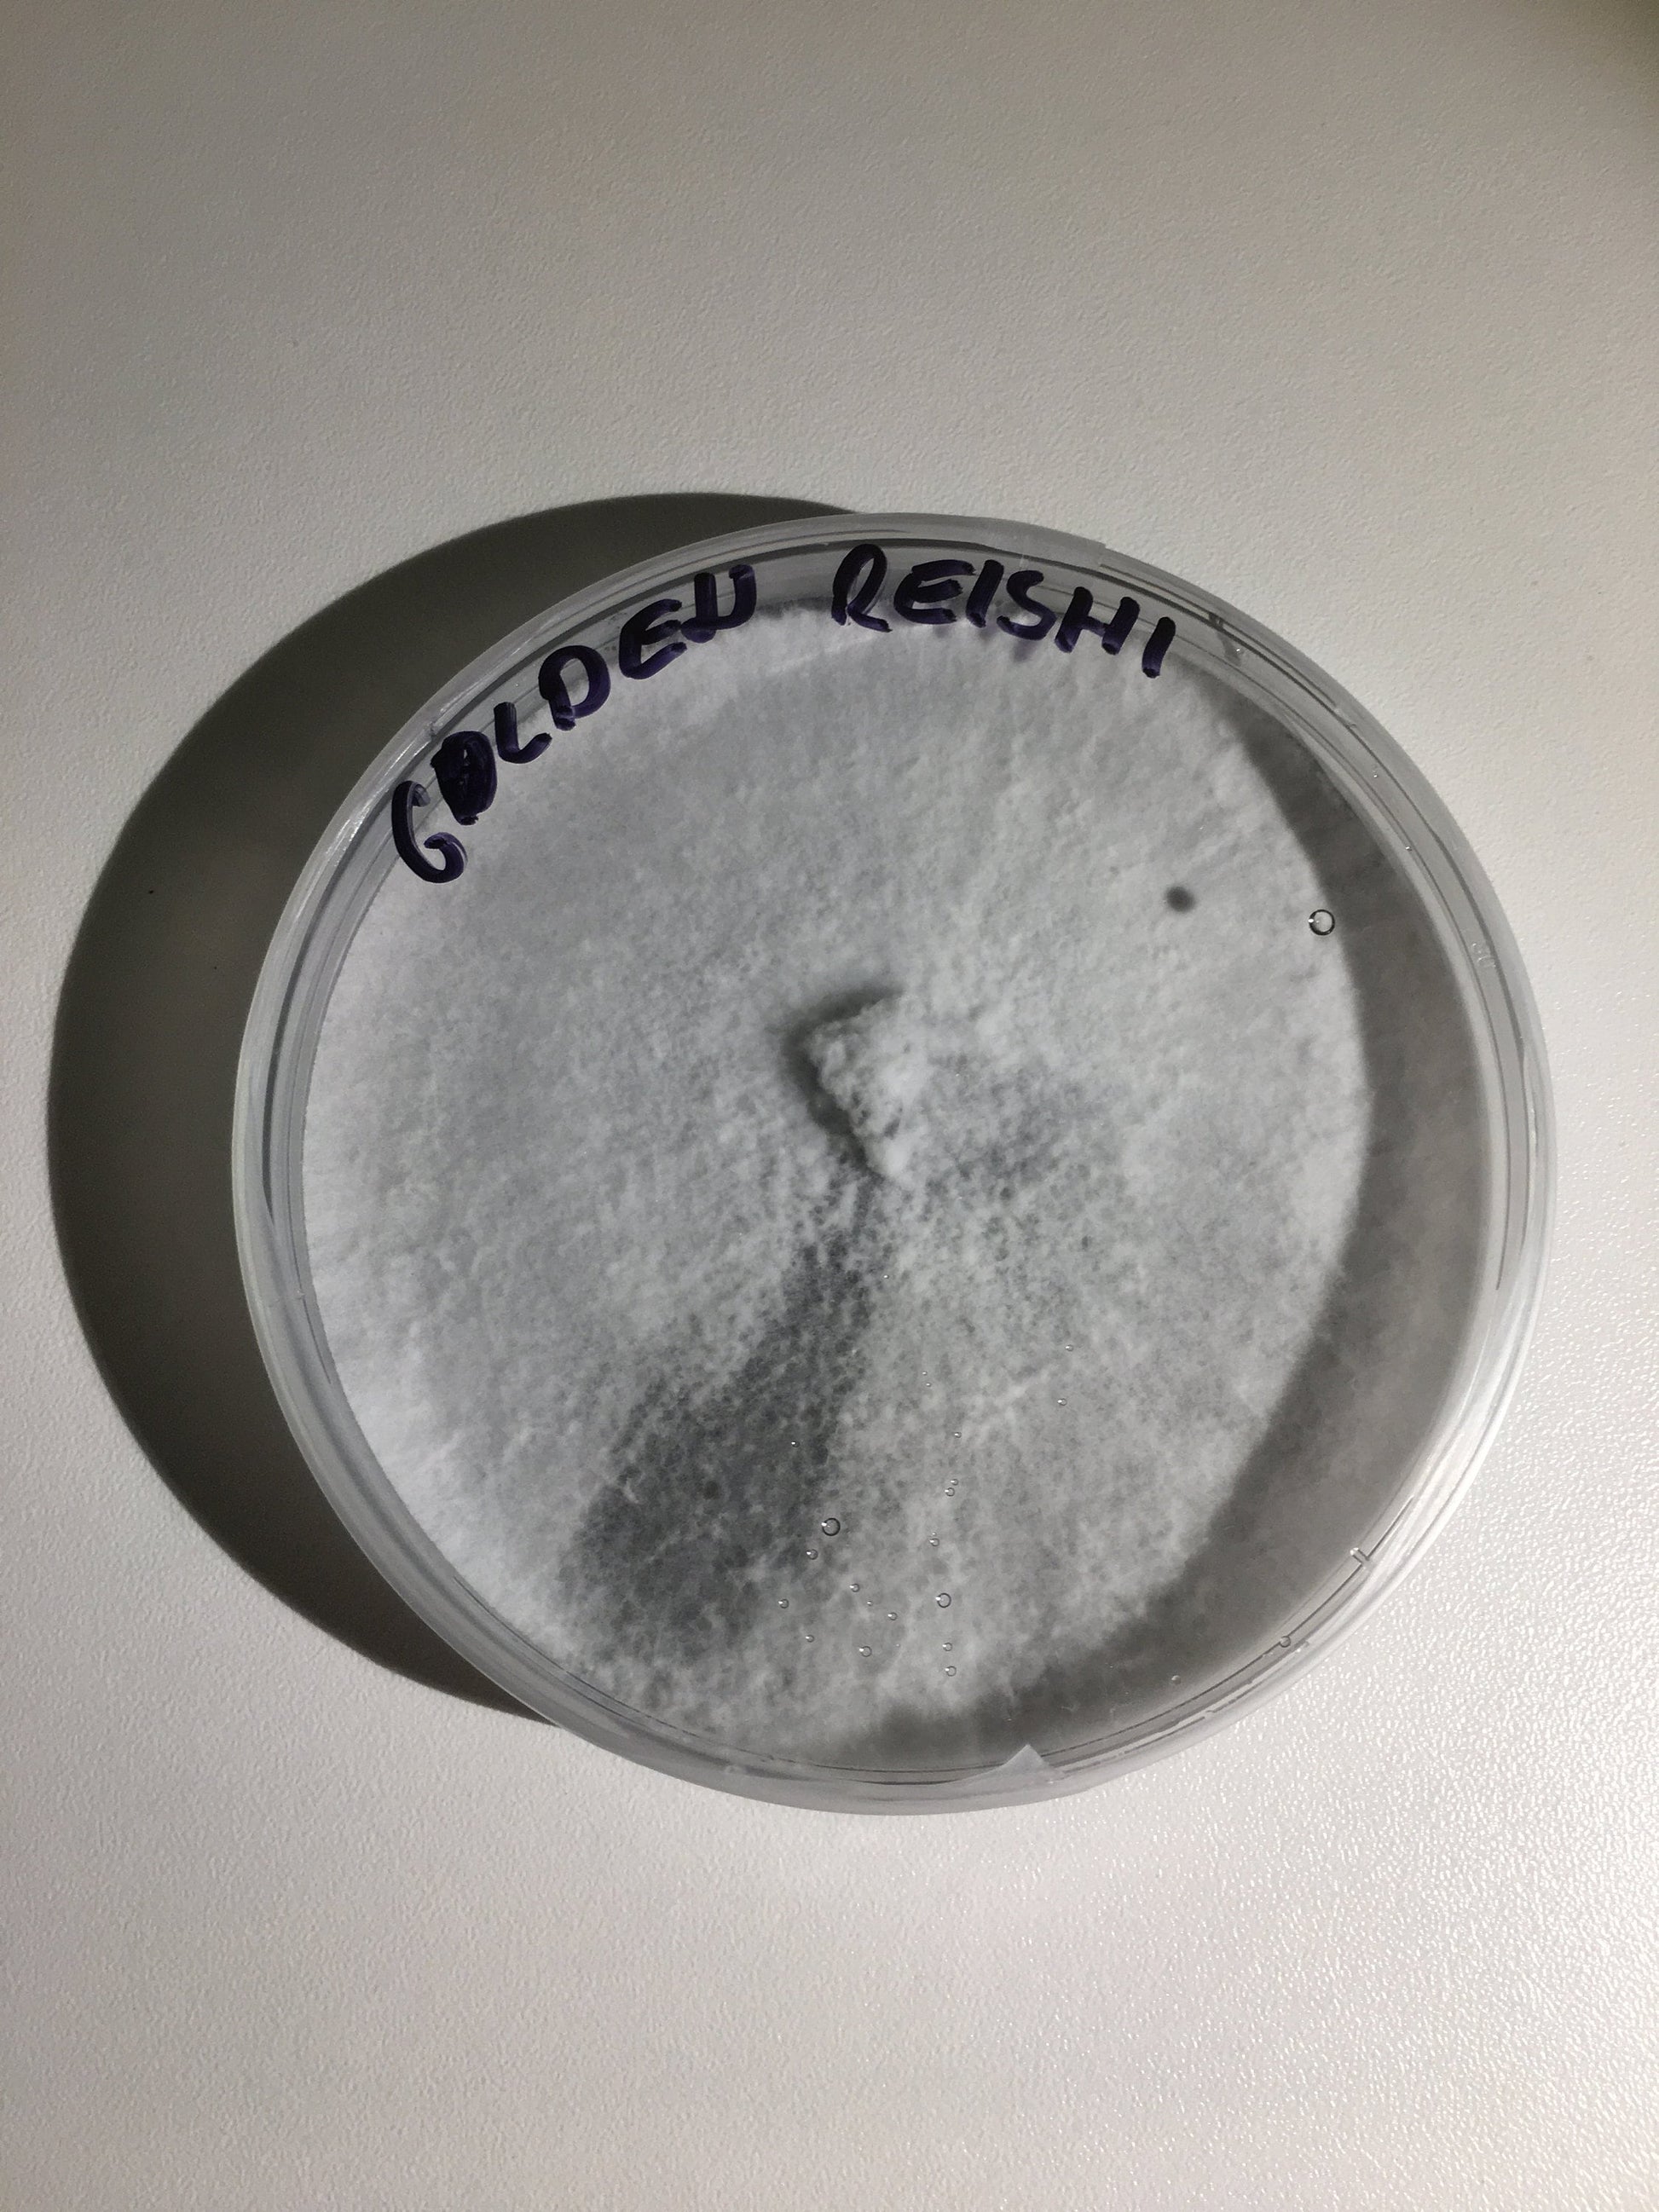

Take Control of Your Cultivation with Freshrooms Mushroom Mother Culture on Agar
Achieve precision in your mushroom cultivation projects with our Mushroom Mother Culture on Agar. This 90mm petri dish comes pre-filled with a clean, living culture of gourmet or medicinal mushrooms, ready to help you expand your growing potential.
Why You’ll Love It:
✅High-Quality Living Culture: Includes a meticulously isolated mushroom culture for optimal growth and colonization.
✅Versatile Applications: Ideal for inoculating grain bags, jars, or serving as a mother culture for further expansion.
✅Perfect for Precision Growing: Designed for growers looking to refine their cultivation techniques with high-performing genetics.
✅Optimal Storage: Best kept refrigerated or in a cool, dark, and dry place to maintain viability.
Designed for Excellence
Our cultures are the result of weeks of isolation to ensure superior genetics and high-performance mycelium. Whether you're looking to grow Lion's Mane, Shiitake, or other wood-loving mushrooms, this culture is your foundation for success.
Order your Freshrooms Mushroom Mother Culture on Agar today and unlock the full potential of your mushroom-growing journey!